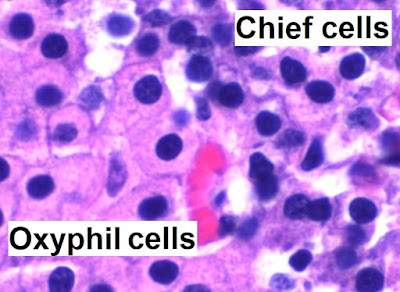

Es un sistema regulador de funciones y procesos, es proveniente del tejido epitelial cuando evagina y forma glándulas endocrinas encargadas de producir mensajeros químicos llamados hormonas que serán transportados por la sangre hasta los órganos receptores denominados órganos blancos
Una hormona es una sustancia química de bajo peso molecular producidas en tejido epitelial que se pueden dividir en 3 categorías
1- Derivadas de aminoácidos. Son aminas aminas adrenalina, noradrenalina, dopamina, hormonas tiroideas y la melatonina.
2- Peptídicas: Son cadenas de aminoácidos como la insulina oxitocina, glucagón, prolactina
3- Lípidos Son esteroides como los estrógenos glucocorticones, andrógenos
Estas hormonas son secretadas en unidades secretoras, es decir, son arreglos o conjuntos que tienen las glándula para formar hormonas. Estas agrupaciones son:
- Rosetas: Están formadas por tejido conjuntivo que delimita a cada roseta las células son las que se en
- Folículos: Es una unidad conformada por coloides (sitio central en donde se produce la hormona) y células foliculares (tejido epitelial)
- Cordones: Unidades que se hayan siempre en dos tiras que pueden estar formando estructuras curvas, rectas, cruzadas o enrolladas
Glándula pituitaria o hipófisis
Es una glándula pequeña que es parte del diencéfalo ubicada en la silla turca del hueso esfenoides. Mide 1cm de diámetro y pesa .5 gramos.
Tiene 2 lóbulos uno llamado adenohipófisis o lóbulo anterior y otro llamado posterior o neurohipófisis, el adenohipófisis proviene del ectodermo oral y del neural, en el oral forma parte de la bolsa de Rathket y en el neural del piso del diencéfalo.
También tienen un infundíbulo que une a los dos lóbulos al hipotálamo; incluso presenta fibras nerviosas que lo conectan con el hipotálamo (pars nervosa)
Presenta 4 regiones:
1.- Pars distalis
Unidad secretora: Roseta
Representa el 75% de toda la glándula, lo que la hace la mas predominante de las 3 regiones
En ella histológicamente se encuentran 3 tipos de células (2 cromófilas y una cromófoba):
Las primeras son las células basófilas, las cuales forman el 15 % de todas las células de la región; como características principales su citoplasma es el mas grandes en comparación con las otras dos, tienen una forma redonda ovoide y con núcleo excéntrico.
La segundas son las células acidófilas que forman el 35% de la pars distalis; su núcleo es rosado y ovoide, tienen gránulos en el citoplasma que también se tiñen de rosa. Tanto las células acidófilas como las basófilas en conjunto forman a las células cromófilas.
Por último están las células cromófobas que son las mas predominantes con un 50% de la región, como su nombre lo dice son células que es difícil que se tiñan por lo que su citoplasma es translucido, no presenta gránulos ademas de que son las células mas pequeñas
2.-Pars intermedia
Unidad secretora: Folículos (mejor conocidos como folículos hipofisiarios)
Representa el 2% de la glándula, se encuentra entre la pars distalis y la nervosa, dividiéndolas.
Se caracterizan por solo tener células basófilas y cromófobas
3.-Pars nervosa
No presenta unidades secretoras
Representa el 23% de la glándula
Esta zona esta formada por fibras nerviosas amielínicas sostenidas por células gliales y pituicitos; ademas de también tener cuerpos de Herring sustancias neurosecretoras teñidas intensamente de oscuro
UNIDAD: cordones
Forma parte del diencéfalo y tiene una estructura semi-aplanada, mide 8 mm de longitud por 5 mm de ancho en el que su parénquima está formada de lobulillos irregulares. Entre sus funciones la mas destacada es la de regular el ciclo circadiano
Se caracteriza por tener pinealocitos, estas, son células especificas de la glándula, en la que se puede identificar su predominante núcleo con escotadura y poco citoplasma. Al encontrarse dentro del encéfalo cuenta con células gliales, mas específicamente astrocitos. En ocasiones se puede observar estructuras llamadas arenilla cerebral que no son mas concreciones de fosfato o carbonato de calcio que aumentan con la edad
Páncreas
UNIDAD: Cordones enrollados
Se encuentra ubicada en la curvatura del duodeno, conformada por cabeza, cuerpo y cola son; esta glándula se divide en lobulillos que están delimitados por tejido conectivo y ayuda a dividir las regiones de este órgano.
Se dice que es una glándula mixta debido a que tiene una porción endocrina y una exocrina, la porción exocrina se encarga de producir enzimas digestivas, mientras que la porción endocrina produce cuatro hormonas:
Cada lobulillo tienen una porción endocrina y una exocrina; la región externa es exocrina (adenómeros acinares de secreción serosa) encargada de secretar proteínas, mientras la región interna es endocrina formada por una estructura llamada islote de Langerhans hecha de cordones enrrollados
Debido a su porción exocrina presenta un conducto excretor que atraviesa toda la glándula para llevar las enzimas al duodeno, a este conducto se le llama conducto de Wirsung
Tiroides
UNIDAD: Folículo tiroideo
Se encuentra en la región cervical en la parte anterior de la laringe, pesa entre 25 a 40 gramos, forma de moño debido a que presenta 2 lóbulos unidos por el istmo
Su unidad, el folículo tiroideo se conforma de células foliculares (epitelio cubico simple) que se encargan de rodear a un coloide que contiene tiroglobulina, asi mismo en la periferia de este folículo también tiene células parafoliculares o células C (Calcitonina), ademas de vasos sanguíneos
![]() |
| 1 y 3: Epitelio folicular 2: Coloide con tiroglobulina 4: Células parafoliculares |
Paratiroides
UNIDAD: Rosetas
Se encuentra en la región posterior de la glándula tiroides, encontrándose un par en cada lóbulo. Miden de 4 a 8 mm de longitud y de 2 a 5 mm de ancho.
Cada glándula está conformada por rosetas hechas a base de células acidófilas y basófilas, y cuenta con tejido conectivo que forma trabéculas que dividen a las glándulas.
Las células basófilas son la células principales de la glándula ya que se encuentran en mayor proporción aunque comparadas con las acidófilas son mas pequeñas, tienen poco citoplasma y de forma poliédrica, su núcleo es redondo.
Por otro lado a las células acidófilas en este órgano se le llaman células oxífilas las cuales son ovoides y son las mas grandes, contando con un gran citoplasma acidófilo, eso si se encuentran en menor cantidad.
![]() |
| Glandula paratoroides rodeada de tejido adiposo |
Glándulas suprarrenales
Son glándulas que se ubican en la región superior del riñón, que se caracterizan por tener forma piramidal y se de color amarillo, estas glándulas están envueltas por tejido adiposo que protege a la capsula constituida de tejido conjuntivo, la corteza hecha de mesodermo y la médula compuesta de ectodermo neural.
Esta glándula se compone de diferentes unidades secretoras que conforman a la corteza, cada unidad forma una capa de la corteza
![]() |
| En la región superior derecha de la imagen es posible ver el tejido adiposo |
Corteza conformada por
Zona glomerular
UNIDAD: Cordones curvos
Representa el 13% de la corteza, su unidad son los cordones curvos aunque algunos libros mencionan que son rosetas, las células tienen forma piramidal o cilíndrica.
Zona fascicular
UNIDAD: cordones rectos
Conforman el 80% de la corteza, los cordones están constituidos por células llamadas espongiocitos; los cordones cuentan con capilares sinusoides que ayudan a dividirlos. Es la zona mas predominante.
Zona reticular
Unidad: cordones cruzados
Solo ocupan el 7% de la corteza, es la capa mas interna en la que sus cordones cruzados están separados por capilares sinusoides.
Médula
UNIDAD: racimos o cordones
La médula esta conformada por células ganglionares, las cuales son neuronas que pertenecen al sistema nervioso periférico es decir son nervios pero no tienen axón. También contiene células cromafines, células que presentan afinidad por el cromato de potasio, tienen forma ovoide y presentan gránulos hechos de catecolaminas. Ademas también es posible encontrar fibras nerviosas. Contiene muchos vasos sanguíneos.








.jpg)